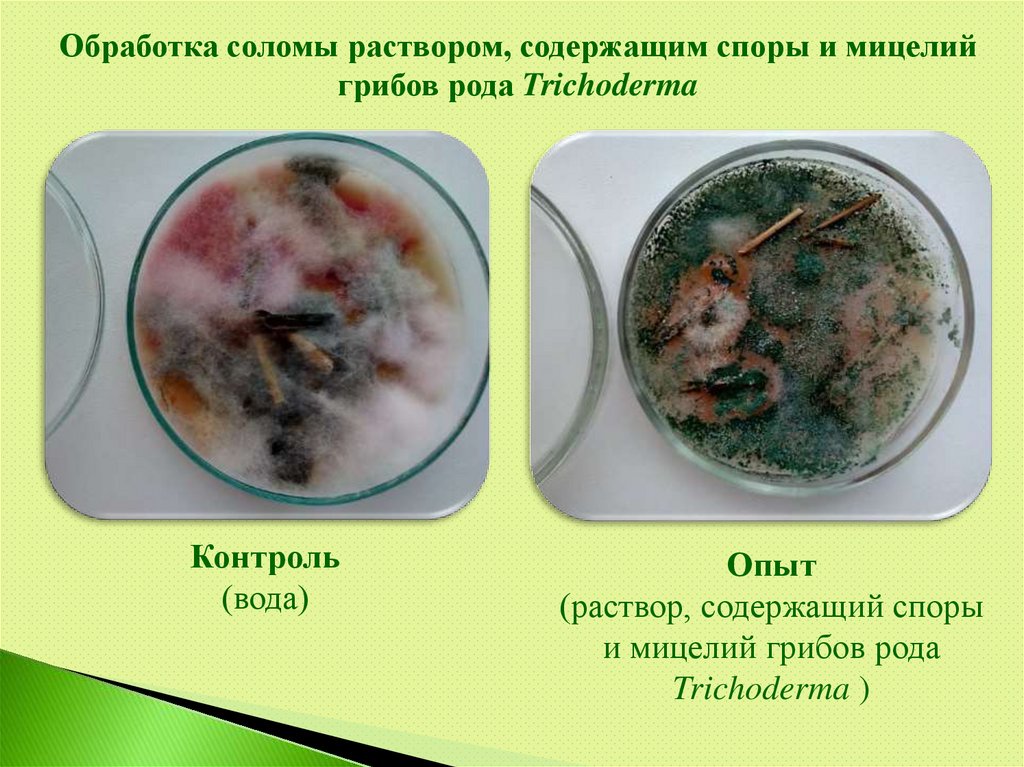

Similar presentations:
Препараты для сельхозтоваропроизводителей в 2022 году
1.
Министерство сельского хозяйстваРоссийской Федерации
Федеральное государственное бюджетное учреждение
«Российский сельскохозяйственный центр»
Филиал ФГБУ «Россельхозцентр» по Республике Марий Эл
Препараты для
сельхозтоваропроизводителей
в 2022 году
Кисельникова Ольга Муратовна
- главный микробиолог ТАЛ
филиал ФГБУ «Россельхозцентр»
по Республике Марий Эл
2.
«Почва пропитана жизнью» В. И. Вернадский3.
Ферментационная установка4.
ПСЕВДОБАКТЕРИН-2, ЖПредпосевная обработка: 1 л/т
Обработка по вегетации: 0,5-1 л/га
Биофунгицид.
Предназначен для борьбы с целым рядом
заболеваний различных сельхозкультур.
Применяется при: - предпосевной обработке семян;
- обработке по вегетации.
Можно применять в составе баковых смесей.
5.
АЗОЛЕН, ЖОбработка по вегетации: 1-3 л/га
Микробиологическое удобрение.
Предназначен для использования в качестве
микробиологического удобрения с фунгицидными и
ростостимулирующими свойствами, а так же
азотофиксирующий способностью.
Применяется при: - предпосевной обработке семян;
- обработке по вегетации.
Можно применять в составе баковых смесей.
6.
ЭФФЕКТ БИО, ЖОбработка растительных остатков: 1,5-5 л/га
Деструктор пожнивных остатков.
Предназначен для ускорения разложения
растительных остатков, регулирования численности
возбудителей заболеваний сельскохозяйственных
культур.
Применяется при обработке растительных остатков
с или без заделки в почву.
7.
Обработка соломы раствором, содержащим споры и мицелийгрибов рода Trichoderma
Контроль
(вода)
Опыт
(раствор, содержащий споры
и мицелий грибов рода
Trichoderma )
8.
ГУМАТ +7 «Здоровый урожай»Предпосевная обработка: 1-1,5 л/т
Обработка по вегетации: 1-2 л/га
Агрохимикат.
Предназначен для использования в качестве
удобрения во время вегетационного периода.
Применяется при: - предпосевной обработке семян;
- обработке по вегетации.
Совместим с пестицидами и биопрепаратами.
9.
10.
11.
Приглашаем к сотрудничеству!Филиал ФГБУ «Россельхозцентр» по РМЭ
г. Йошкар-Ола, ул. Тельмана, 56
тел.: 46-37-00 (факс); 46-37-40 (отд. реализации)

biology
biology








